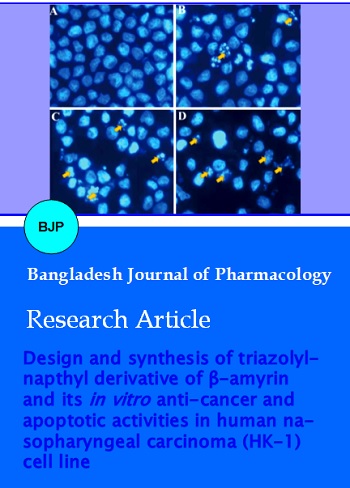

Established by INASP in 2007. Managed by Bangladesh Academy of Sciences.
Bangladesh Journals Online (BanglaJOL) is a service to provide online publication of Bangladeshi journals. For more information about BanglaJOL and how to join the service, see the About page.